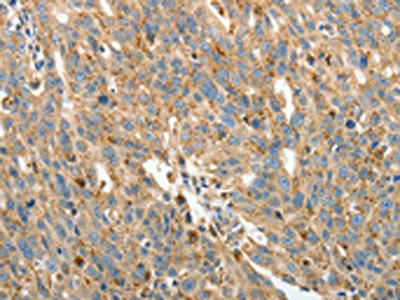

-
中文名稱:PRCP兔多克隆抗體
-
貨號:CSB-PA921139
-
規格:¥1100
-
圖片:
-
The image on the left is immunohistochemistry of paraffin-embedded Human liver cancer tissue using CSB-PA921139(PRCP Antibody) at dilution 1/15, on the right is treated with fusion protein. (Original magnification: ×200)
-
The image on the left is immunohistochemistry of paraffin-embedded Human ovarian cancer tissue using CSB-PA921139(PRCP Antibody) at dilution 1/15, on the right is treated with fusion protein. (Original magnification: ×200)
-
Gel: 10%SDS-PAGE, Lysate: 50 μg, Lane 1-3: SKOV3 cells, A549 cells, human liver cancer tissue, Primary antibody: CSB-PA921139(PRCP Antibody) at dilution 1/100, Secondary antibody: Goat anti rabbit IgG at 1/8000 dilution, Exposure time: 5 minutes
-
-
其他:
產品詳情
-
Uniprot No.:
-
基因名:
-
別名:Angiotensinase C antibody; HUMPCP antibody; Lysosomal carboxypeptidase C antibody; Lysosomal Pro X carboxypeptidase antibody; Lysosomal Pro-X carboxypeptidase antibody; MGC2202 antibody; PCP antibody; PCP_HUMAN antibody; PRCP antibody; Proline carboxypeptidase antibody; Prolylcarboxypeptidase (angiotensinase C) antibody; Prolylcarboxypeptidase antibody; prolylcarboxypeptidase isoform 1 preproprotein antibody
-
宿主:Rabbit
-
反應種屬:Human,Mouse
-
免疫原:Fusion protein of Human PRCP
-
免疫原種屬:Homo sapiens (Human)
-
標記方式:Non-conjugated
-
抗體亞型:IgG
-
純化方式:Antigen affinity purification
-
濃度:It differs from different batches. Please contact us to confirm it.
-
保存緩沖液:-20°C, pH7.4 PBS, 0.05% NaN3, 40% Glycerol
-
產品提供形式:Liquid
-
應用范圍:ELISA,WB,IHC
-
推薦稀釋比:
Application Recommended Dilution ELISA 1:1000-1:2000 WB 1:200-1:1000 IHC 1:25-1:100 -
Protocols:
-
儲存條件:Upon receipt, store at -20°C or -80°C. Avoid repeated freeze.
-
貨期:Basically, we can dispatch the products out in 1-3 working days after receiving your orders. Delivery time maybe differs from different purchasing way or location, please kindly consult your local distributors for specific delivery time.
-
用途:For Research Use Only. Not for use in diagnostic or therapeutic procedures.
相關產品
靶點詳情
-
功能:Cleaves C-terminal amino acids linked to proline in peptides such as angiotensin II, III and des-Arg9-bradykinin. This cleavage occurs at acidic pH, but enzymatic activity is retained with some substrates at neutral pH.
-
基因功能參考文獻:
- For the first time, PRCP is identified as an apelin-cleaving enzyme. PMID: 27449720
- The decrease in PRCP levels in the first 24 h after stroke onset is associated with stroke severity and an unfavourable short-term stroke outcome PMID: 25370794
- PRCP1 interacts with plasma kallikrein (PK) at multiple sites for PK activation. PMID: 25324000
- The present results indicated PRCP rs7104980 can be considered as a marker for EH and Hap3 GAGCACTAACA (PRCP) and Hap16 TTTA (CMA1) might be associated with essential hypertension in Chinese Han population. PMID: 22679278
- PRCP regulates cell growth, angiogenesis, and the response to vascular injury PMID: 23744584
- analysis of non-benzimidazole and brain-penetrant prolylcarboxypeptidase inhibitors PMID: 22079761
- PRCP as a resistance factor for 4OHTAM resistance in estrogen receptor-positive breast cancer cells. PMID: 21087932
- A single peptide, with the sequence YPRPIHPA, as a novel substrate for PRCP in human cerebrospinal fluid. PMID: 20517885
- Purified PrCP yielded crystals belonging to space group R32, with unit-cell parameters a = b = 181.14, c = 240.13 A, that diffracted to better than 2.8 A resolution. PMID: 20516604
- A structure-based alignment with the previously undescribed structure of DPP7 illuminates the mechanism of orthogonal substrate specificity of PRCP and DPP7. PMID: 20540760
- Data suggest that the E112D polymorphism in the PRCP gene may be a useful genetic marker to predict the antihypertensive effect of short-term benazepril treatment in hypertensive patients. PMID: 20079160
- PRCP appears to be a HUVEC-associated prekallikrein activator. PMID: 11830581
- Identification of prolylcarboxypeptidase as the cell matrix-associated prekallikrein activator. PMID: 12123826
- recombinant protein, identical to enzyme from human umbilical vein endothelial cells, is a prekallikrein activator. PMID: 14996700
- Prolylcarboxypepdiase E112D (rs2298668)D allele alone and jointly with chronic hypertension were associated with a significantly increased risk of preeclampsia PMID: 16681991
- role in regulation cardiovascular tone; proinflammatory agent PMID: 18396440
- These investigations showed that the C-terminal region of the rPRCP(40) contributes to PRCP's catalytic function, and provided additional experimental evidence for this suggestion. PMID: 18656443
顯示更多
收起更多
-
亞細胞定位:Lysosome.
-
蛋白家族:Peptidase S28 family
-
組織特異性:Highest levels in placenta, lung and liver. Also present in heart, brain, pancreas and kidney.
-
數據庫鏈接:
Most popular with customers
-
-
YWHAB Recombinant Monoclonal Antibody
Applications: ELISA, WB, IHC, IF, FC
Species Reactivity: Human, Mouse, Rat
-
Phospho-YAP1 (S127) Recombinant Monoclonal Antibody
Applications: ELISA, WB, IHC
Species Reactivity: Human
-
-
-
-
-